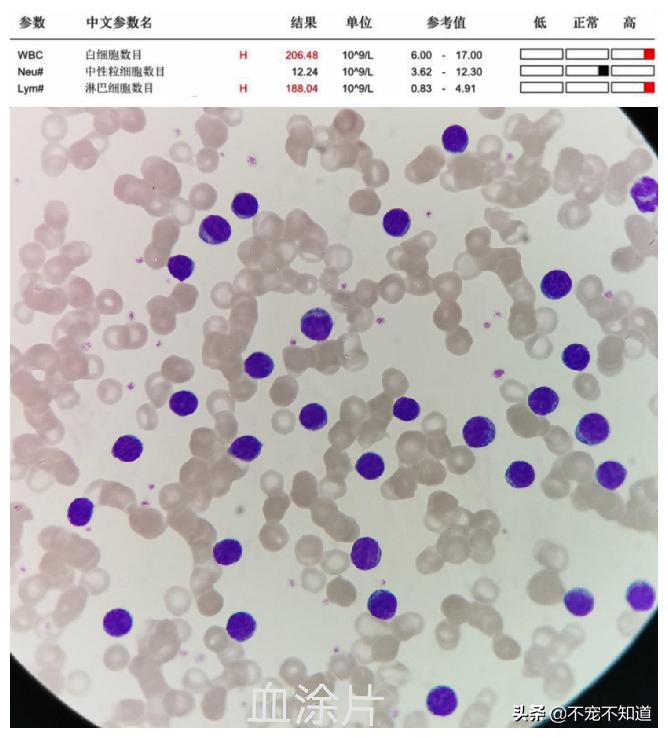
狗狗淋巴肿大，有可能是患了白血病

来源:维特深圳动物医院
很多时候,重症疾病不一定会有很严重的症状表现,身体突然出现的小小肿块,就可能是巨大的隐患!
就像这只狗狗,家长原本以为它只是淋巴结肿大,结果却发现是患了白血病!
01只是检查个肿块,却发现有白血病?
狗狗香奈儿最近发现淋巴肿大,家长带着它来到维特(深圳)动物医院检查。
张林玉医生为狗狗进行血常规、生化等全面体检后,发现狗狗白细胞数量高达206.48*10^9/L ,比正常值高出将近34倍!其中淋巴细胞数量高达188*10^9/L,约为正常值的47倍。
经过外周淋巴结细胞学检查,显示狗狗可能有小细胞性淋巴瘤。
随即配合生物分子生物学(PARR—PCR)方式做进一步检查,淋巴细胞分型显示B细胞为单克隆增殖。
B细胞又称B淋巴细胞,当它出现单克隆增殖,说明该细胞出现肿瘤性病变。

(狗狗外周淋巴结细胞学检查结果)

(狗狗PARR—PCR检查结果)
综合所有检查,张医生最终确诊,狗狗患有慢性B淋巴细胞白血病(B-CLL)。
02白血病不能治?好方案有效延续生命
听到“白血病”3个字,许多家长就会担心,患了白血病的狗狗是不是无法痊愈?
实际上白血病并非无法治疗和控制,特别是慢性淋巴细胞白血病,采取完善的治疗方案,同时长期监控狗狗各项身体指标,就能最大程度有效抑制病情恶化。
综合香奈儿的情况,张林玉医生为狗狗制定了科学的治疗方案,并定期监测狗狗血液中的白细胞计数。
接受治疗后,香奈儿情况一直很稳定,白细胞数量逐步恢复正常。
期间,狗狗曾短暂出现肝肾指数轻度升高的情况,张医生及时发现,立马调整用药剂量。调整后,狗狗肝肾指数很快复原,且没有影响狗狗情况恢复,说明治疗方案很有效!
经过3个月的治疗,狗狗淋巴细胞计数从最开始的188*10^9/L,逐步降到 8.7 *10^9/L!
这已经很接近0.83-4.91*10^9/L的正常范围数值了,全身淋巴结也基本恢复正常。

治疗5个月后,狗狗外周血液淋巴细胞数量已经恢复正常,遂停止用药,并长期监测狗狗白细胞数量,防止复发。

(狗狗外周血液淋巴细胞数量恢复正常,停止用药)
停药观察6个多月,狗狗情况稳定,至今也未见复发的迹象。接下来,依旧需定期每月监测狗狗白细胞数量。
这是一个漫长的过程,也是个充满希望的过程:只要治疗方式得当、长期监测,狗狗的生命就能够得到有效延续。
03小肿块有大问题,平时检查要及时!
狗狗慢性淋巴细胞白血病,是由狗狗血液中的淋巴细胞系癌细胞引起的慢性疾病。该病表现为血液中淋巴细胞数量激增,会破坏狗狗免疫系统、造血系统,严重危害狗狗生命健康!
慢性淋巴细胞白血病的症状往往不明显,通常表现为淋巴结肿大、脾肿大、嗜睡、贫血、出现瘀伤或突然出血等,容易被忽视。
而且很多时候患了白血病的狗狗需要通过实验室检查才能最终确诊,因此,各位铲屎官平时一定要定时体检,才能第一时间揪出隐患,及时治疗,更好保障毛孩子生命健康!